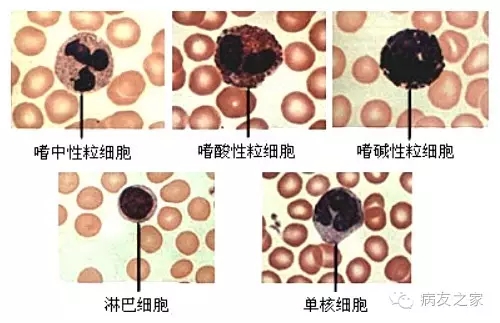
3.webp.jpg 3.webp.jpg

患教課堂◆看懂血常規(guī)之血液三兄弟之白細(xì)胞
血常規(guī)是大家做的最多的一種檢查,也是小編在群里解答的最多一類問題,看著血常規(guī)檢查單中出現(xiàn)的上上下下的箭頭,都有種不知所以的擔(dān)心,好吧,“授之以漁不如授之以漁”,整理血常規(guī)三系,讓我們都來看懂血常規(guī)、了解血常規(guī)。

白細(xì)胞舊稱白血球。血液中的一類細(xì)胞。白細(xì)胞也通常被稱為免疫細(xì)胞。
白細(xì)胞能吞噬異物,漿細(xì)胞產(chǎn)生抗體,在機(jī)體損傷治愈、抗御病原的入侵和對疾病的免疫方面起著重要的作用。機(jī)體發(fā)生炎癥或其他疾病都可引起白細(xì)胞總數(shù)及各種白細(xì)胞的百分比發(fā)生變化,因此檢查白細(xì)胞總數(shù)及白細(xì)胞分類計(jì)數(shù)成為輔助診斷的一種重要方法。
正常成人血液中的白細(xì)胞數(shù)目為(4.0~10.0)×10^ 9/L.兒童和嬰幼兒則完全不同。新生兒出生時白細(xì)胞數(shù)量可達(dá)到(15~20)×10^9/L,在隨后的一周中可降至15×10^9/L左右,在2歲以內(nèi)可達(dá)到(10~12)×10^9/L,在5歲以下兒童也往往高于成人水平,平均值在8×10^9/L左右,以后隨著年齡的長大,逐漸接近成人水平。其實(shí)白細(xì)胞還可以細(xì)分為五種類型,使用儀器或人工方法對這五類細(xì)胞分別計(jì)數(shù),被稱為白細(xì)胞分類計(jì)數(shù)。這五類白細(xì)胞中嗜中性粒細(xì)胞占50%~70%,淋巴細(xì)胞占20%~40%,單核細(xì)胞占3%~8%,嗜酸性粒細(xì)胞占1%~5%,嗜堿性粒細(xì)胞不超過1%。
(一)機(jī)體有炎癥(即發(fā)炎)時會出現(xiàn)白細(xì)胞增多;一般白細(xì)胞少的原因有;病毒感染、傷寒等、也有因?yàn)樗幬镆鸬摹?/h2>
1、白細(xì)胞病理性增高非常重要,應(yīng)該根據(jù)患者的具體病情進(jìn)行分析判斷。急性細(xì)菌性感染白細(xì)胞會迅速升高,而且和感染程度呈正比。例如患者常因感冒、發(fā)熱、咳嗽、疼痛等癥狀到醫(yī)院看病,醫(yī)生多通過白細(xì)胞數(shù)量的變化初步判斷是否因細(xì)菌性感染而造成以上的臨床癥狀

a)當(dāng)發(fā)生感染時,白細(xì)胞中數(shù)量最多的嗜中性粒細(xì)胞和嗜酸性粒細(xì)胞會迅速出現(xiàn)(表現(xiàn)為白細(xì)胞數(shù)量的增多),吞噬入侵人體的細(xì)菌、寄生蟲等病原體。而且這種細(xì)菌性感染程度往往與白細(xì)胞數(shù)量升高成正比。
b)白細(xì)胞不升高往往被看作是病毒入侵導(dǎo)致的感染,白細(xì)胞升高呈幅度較小、緩慢的狀態(tài)。
c)此外各種組織損傷、外傷、手術(shù)后、急性失血、中毒、惡性腫瘤、急性中毒等白細(xì)胞也會有明顯升高,但這要根據(jù)患者的情況和其他檢查手段進(jìn)行判斷和分析。
d)除了這些病理性的原因,還有生理性原因如月經(jīng)前后、妊娠、分娩期婦女、劇烈運(yùn)動、興奮激動、飲酒等也會引起白細(xì)胞增多。因此在看到白細(xì)胞升高時,不要妄下診斷,有可能是生理性原因引起的。
白細(xì)胞升高最嚴(yán)重的問題是造血系統(tǒng)的惡性腫瘤,也就是白血病,其白細(xì)胞常會明顯升高,其升高幅度可以是正常人的數(shù)倍或數(shù)十倍以上。此類患者不僅白細(xì)胞數(shù)量出現(xiàn)明顯改變,更重要的是其質(zhì)量發(fā)生重要變化,大量幼稚細(xì)胞出現(xiàn)在外周血液中。白血病有許多類型,可分為急性與慢性,此時不僅僅要看白細(xì)胞數(shù)量,還需要做血涂片甚至骨髓穿刺檢查、流式細(xì)胞分析和分子生物學(xué)檢查才能確認(rèn)。
2、當(dāng)白細(xì)胞數(shù)量低于4×10^9/L時被稱為白細(xì)胞減少,但其臨界值往往設(shè)定為(2.5~4)×10^9/L,也就是說低于2.5時肯定考慮為異常。白細(xì)胞數(shù)量明顯減少也是不可忽視的問題,長期接觸放射線、各種理化因素導(dǎo)致的中毒、腫瘤的化療和放療、脾功能亢進(jìn)、自身免疫病、再生障礙性貧血、造血功能障礙等都會導(dǎo)致白細(xì)胞特別是中性粒細(xì)胞減少,當(dāng)然這些疾病的診斷還要依靠其他的檢查手段才能確定。應(yīng)該注意的是,當(dāng)白細(xì)胞數(shù)量明顯減少,特別是中性粒細(xì)胞低于1.0×10^9/L時,非常容易發(fā)生感染、反復(fù)感染,且疾病治愈較為緩慢,甚至可以引發(fā)敗血癥,此時一定要引起患者本人和臨床醫(yī)師的高度重視。
3、如系藥物等引起的粒細(xì)胞減少,應(yīng)立即停藥,適當(dāng)應(yīng)用生白藥物,如集落刺激因子(CsF)、碳酸鋰、茜草雙酯、多抗甲素等。停止接觸放射線或其他化學(xué)毒物。由脾功能亢進(jìn)引起的,易發(fā)生反復(fù),嚴(yán)重感染,可做脾切除術(shù)。
4、當(dāng)患者正在服用磺胺類藥物、解熱鎮(zhèn)痛藥、部分抗生素(如頭孢類)、抗甲狀腺或者抗腫瘤藥物時,都會引起白細(xì)胞減少,這時停用即可恢復(fù)。
(二)白細(xì)胞根據(jù)形態(tài)差異可分為顆粒和無顆粒兩大類。三種顆粒白細(xì)胞即中性粒細(xì)胞、嗜酸性粒細(xì)胞和嗜堿性粒細(xì)胞。無顆粒白細(xì)胞無細(xì)胞質(zhì)顆粒,但有圓形細(xì)胞核,包括單核細(xì)胞和淋巴細(xì)胞。
1、中性粒細(xì)胞的生命周期為一周左右,是機(jī)體對抗入侵病菌,特別是急性化膿性細(xì)菌的最重要的防衛(wèi)系統(tǒng)。當(dāng)中性粒細(xì)胞數(shù)顯著減少時,機(jī)體發(fā)生感染的機(jī)會明顯增高,中性粒細(xì)胞病理性增多。
急性化膿性感染時,中性粒細(xì)胞增高程度取決于感染微生物的種類、感染灶的范圍、感染的嚴(yán)重程度、患者的反應(yīng)能力。如感染很局限且輕微,白細(xì)胞總數(shù)仍可正常,但分類檢查時可見分葉核百分率有所增高;中度感染時,白細(xì)胞總數(shù)增高大于10×109/L,并伴有輕度核象左移;嚴(yán)重感染時總數(shù)常明顯增高,可達(dá)20×109/L以上,且伴有明顯核象左移;在脾破裂或?qū)m外孕輸卵管破裂后,白細(xì)胞迅速增高,常達(dá)(20~30)×109/L。其增多的細(xì)胞主要是中性分葉核粒細(xì)胞。這可能與應(yīng)激狀態(tài)、內(nèi)出血而一過性缺氧等有關(guān);化學(xué)藥物如安眠藥、敵敵畏等中毒時,常見白細(xì)胞數(shù)增高,甚至可達(dá)20×109/L或更高。代謝性中毒如糖尿病酮癥酸中毒及慢性腎炎尿毒癥時,也常見白細(xì)胞增多。均以中性分葉核粒細(xì)胞為主。白細(xì)胞呈長期持續(xù)性增多,最常見于粒細(xì)胞性白血病,其次也可見于各種惡性腫瘤的晚期,此時不但總數(shù)常達(dá)(10~20)×109/L或更多,且可有較明顯的核象左移現(xiàn)象,而呈所謂類白血病反應(yīng)。
某些感染,如傷寒、副傷寒、瘧疾、流感等可引起白細(xì)胞減少;某些血液病,如再生障礙性貧血時,呈“三少”表現(xiàn);電離輻射(如X線等)、長期服用氯霉素后,可因抑制骨髓細(xì)胞的有絲分裂而致白細(xì)胞減少;自身免疫性疾病如系統(tǒng)性紅斑狼瘡等,由于自身免疫性抗核抗體導(dǎo)致白細(xì)胞破壞而減少;各種原因所致的脾腫大均可見白細(xì)胞減少。
2、嗜酸性粒細(xì)胞具有粗大的嗜酸性顆粒,顆粒內(nèi)含有過氧化物酶和酸性磷酸酶。嗜酸性粒細(xì)胞具有趨化性,能吞噬抗原抗體復(fù)合物,減輕其對機(jī)體的損害,并能對抗組織胺等致炎因子的作用。有吞噬作用和趨化作用。
·支氣管哮喘、血管神經(jīng)性水腫、食物過敏、精神病時均可見血中嗜酸性粒細(xì)胞增多。
·手術(shù)和燒傷病人的預(yù)后及測定腎上腺皮質(zhì)功能。腫瘤性增高見于淋巴系統(tǒng)惡性疾患、血液病、慢性白血病等。慢性粒細(xì)胞性白血病患者嗜酸性粒細(xì)胞??筛哌_(dá)10%以上,并可見有幼稚型。
·寄生蟲感染是嗜酸粒細(xì)胞增多最常見的原因單細(xì)胞的原蟲感染一般不引起嗜酸粒細(xì)胞增高,而多細(xì)胞的蠕蟲、吸蟲可引起嗜酸粒細(xì)胞增多,其程度與蟲體,特別是幼蟲侵入組織的數(shù)量和范圍相平行。限于腸道腔內(nèi)的感染如:蛔蟲、絳蟲,一般不引起嗜酸粒細(xì)胞增多。
·變態(tài)反應(yīng)性疾病包括過敏性鼻炎、支氣管哮喘、蕁麻疹、血管神經(jīng)性水腫、藥物過敏反應(yīng)等均可出現(xiàn)嗜酸粒細(xì)胞增多。藥物過敏反應(yīng)可僅表現(xiàn)為嗜酸粒細(xì)胞增多
·感染性疾病急性細(xì)菌和病毒感染常可引起嗜酸粒細(xì)胞增高,在恢復(fù)期大多回復(fù)正常。有的真菌(曲菌和球孢子菌)病和慢性結(jié)核病亦可見嗜酸粒細(xì)胞增多。
·嗜酸性粒細(xì)胞減少見于傷寒、副傷寒、手術(shù)后嚴(yán)重組織損傷以及應(yīng)用腎上腺皮質(zhì)激素或促腎上腺皮質(zhì)激素后,一臨床意義不大
3、嗜堿性粒細(xì)胞中有嗜堿性顆粒,內(nèi)含組織胺、肝素與5-羥色胺等生物活性物質(zhì),在抗原-抗體反應(yīng)時釋放出來。嗜酸性粒細(xì)胞增高常出現(xiàn)在過敏反應(yīng)的情況下。嗜堿性粒細(xì)胞增高通常出現(xiàn)在:
·一些過敏性疾病如食物的超敏反應(yīng)或者流感等傳染性疾病應(yīng)激反應(yīng),如心梗、嚴(yán)重感染、出血等。有趨化作用和弱吞噬作用。
·增多見于慢性粒細(xì)胞白血病、霍奇金病、癌轉(zhuǎn)移、鉛和鉍中毒等。罕見的嗜堿性粒細(xì)胞性白血病異常增多,可達(dá)20%以上,多為幼稚型。
·骨髓纖維化和某些轉(zhuǎn)移癌時也可見增多。
4、單核細(xì)胞是血液中最大的血細(xì)胞。出生后兩周的嬰兒可出現(xiàn)生理性單核細(xì)胞增多達(dá)到15%,甚至更多;兒童期的單細(xì)胞較成人多,平均約9%。目前認(rèn)為它是巨噬細(xì)胞的前身,具有明顯的變形運(yùn)動,能吞噬、清除受傷、衰老的細(xì)胞及其碎片。單核細(xì)胞還參與免疫反應(yīng),在吞噬抗原后將所攜帶的抗原決定簇轉(zhuǎn)交給淋巴細(xì)胞,誘導(dǎo)淋巴細(xì)胞的特異性免疫反應(yīng)。單核細(xì)胞也是對付細(xì)胞內(nèi)致病細(xì)菌和寄生蟲的主要細(xì)胞防衛(wèi)系統(tǒng),還具有識別和殺傷腫瘤細(xì)胞的能力。單核細(xì)胞增加常發(fā)生于病理性增多見于:
·某些感染。如亞急性感染性心內(nèi)膜炎、瘧疾、黑熱病等;急性感染的恢復(fù)期也可見單核細(xì)胞增多;
·在活動性肺結(jié)核如嚴(yán)重的浸潤性和粟粒性結(jié)核時,可致血中單核細(xì)胞明顯增多。粒細(xì)胞缺乏癥的恢復(fù)期。
·常見單核細(xì)胞一過性增多、惡性組織細(xì)胞病,淋巴瘤時可見幼稚單核細(xì)胞增多,成熟型亦見增多。骨髓增生異常綜合征時除貧血,白細(xì)胞減少等之外,白細(xì)胞分類時常見核細(xì)胞增多。
·粒細(xì)胞缺乏癥恢復(fù)期、惡性組織細(xì)胞病、骨髓增生異常綜合癥、淋巴瘤、惡性組織性疾病等。
5、淋巴細(xì)胞也稱免疫細(xì)胞,淋巴細(xì)胞的主要功能是參與體液免疫、細(xì)胞免疫和分泌淋巴因子。在機(jī)體特異性免疫過程中起主要作用。所謂特異性免疫,就是淋巴細(xì)胞針對某一種特異性抗原,產(chǎn)生與之相對應(yīng)的抗體或進(jìn)行局部性細(xì)胞反應(yīng),以殺滅特異性抗原。初生嬰兒、兒童屬生理性增多。
淋巴細(xì)胞增高多見于病毒性感染、百日咳、傳染性單核細(xì)胞增多癥、急性傳染性淋巴細(xì)胞增多癥、淋巴細(xì)胞性白血病;
·見于急、慢性淋巴細(xì)胞白血??;某些感染:如病毒感染性疾病、細(xì)菌性感染(如百日咳)、結(jié)核感染恢復(fù)期等。
·腎移植術(shù)后如發(fā)生排異反應(yīng)時,于排異前期,淋巴細(xì)胞的絕對值即增高。淋巴細(xì)胞性白血病、白血性淋巴肉瘤前者如系慢性型,以白血病性成熟淋巴細(xì)胞為主,如系急性型則以原幼淋巴細(xì)胞為主,均可致白細(xì)胞總數(shù)增高;后者多以原、幼淋巴細(xì)胞為主。淋巴細(xì)胞減少主要見于長期接觸放射線及應(yīng)用腎上腺皮質(zhì)激素或促腎上腺皮質(zhì)激素治療后人群。
·嚴(yán)重化膿性感染時,由于中性粒細(xì)胞顯著增加,導(dǎo)致淋巴細(xì)胞相對減低。
·淋巴細(xì)胞降低多見于免疫缺陷、放射病。
應(yīng)該注意的是,當(dāng)白細(xì)胞數(shù)量明顯減少,特別是中性粒細(xì)胞低于1.0×10^9/L時,非常容易發(fā)生感染、反復(fù)感染,且疾病治愈較為緩慢,甚至可以引發(fā)敗血癥,此時一定要引起患者本人和臨床醫(yī)師的高度重視。
做血常規(guī)是建議加一個CRP檢查(感染指標(biāo)),很多陰性細(xì)菌感染性疾病白細(xì)胞不高,但是病情進(jìn)展快??股氐氖褂靡卜株栃跃完幮跃?,多檢查一項(xiàng),今早治療??炊R?guī)并不代表你就是醫(yī)生了,建議合理檢查,正規(guī)就醫(yī)。
來源于北京北一
相關(guān)資訊
推薦產(chǎn)品

- 暢明鼻腔沖洗瓶
- 暢明鼻腔沖洗瓶,醫(yī)用高分子材料,聚乙烯聚丙烯 規(guī)格:50ml、250ml、500ml

- 德國DMG硅橡膠印模材料(重體)
- 德國DMG硅橡膠印模材料(重體)

- 防飛沫一次性開口器
- 一次性開口器,防飛沫開口器,強(qiáng)力抽吸口腔飛沫氣溶膠,簡單、快速、高效,一步到位。 科貿(mào)嘉友029-88651307
熱銷產(chǎn)品推薦
相關(guān)醫(yī)療熱點(diǎn)
- 多地下調(diào)種植牙服務(wù)費(fèi)
- 中華口腔醫(yī)學(xué)會關(guān)于堅(jiān)決抵制口腔醫(yī)療美容亂象的聲明
- 重磅|腦死亡立法已獲通過
- 全國首例"醫(yī)告官"案二審將開庭!湖南醫(yī)生實(shí)名舉報辦案人員玩忽職守!
- 中國人的健康大數(shù)據(jù)出來了,慘不慘,自己看
- 剛剛,這段17分鐘的視頻,震顫了國人靈魂!用流量也要看完!吳孟超
- 資本與醫(yī)療
- 政協(xié)委員想問您,您的牙,多久沒有體檢了。
- 一省大風(fēng)暴!醫(yī)院停用大量耗材! 科貿(mào)嘉友收錄
- 未來醫(yī)療的十大趨勢預(yù)判:大醫(yī)院將普遍困難,小診所、??漆t(yī)院獲認(rèn)可 科貿(mào)嘉友收錄












